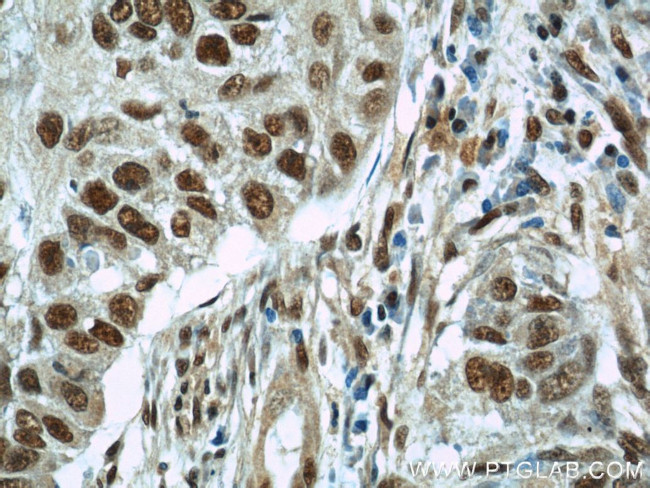
SART3 Antibody in Immunohistochemistry (Paraffin) (IHC (P))

Search
Proteintech
SART3 Polyclonal Antibody
{{$productOrderCtrl.translations['antibody.pdp.commerceCard.promotion.promotions']}}
{{$productOrderCtrl.translations['antibody.pdp.commerceCard.promotion.viewpromo']}}
{{$productOrderCtrl.translations['antibody.pdp.commerceCard.promotion.promocode']}}: {{promo.promoCode}} {{promo.promoTitle}} {{promo.promoDescription}}. {{$productOrderCtrl.translations['antibody.pdp.commerceCard.promotion.learnmore']}}
产品信息
18025-1-AP
种属反应
已发表种属
宿主/亚型
分类
类型
抗原
偶联物
形式
浓度
规格
纯化类型
保存液
内含物
保存条件
运输条件
产品详细信息
Immunogen sequence: MATAAETSA SEPEAESKAG PKADGEEDEV KAARTRRKVL SRAVAAATYK TMGPAWDQQE EGVSESDGDE YAMASSAESS PGEYEWEYDE EEEKNQLEIE RLEEQLSINV YDYNCHVDLI RLLRLEGELT KVRMARQKMS EIFPLTEELW LEWLHDEISM AQDGLDREHV YDLFEKAVKD YICPNIWLEY GQYSVGGIGQ KGGLEKVRSV FERALSSVGL HMTKGLALWE AYREFESAIV EAARLEKVHS LFRRQLAIPL YDMEATFAEY EEWSEDPIPE SVIQNYNKAL QQLEKYKPYE EALLQAEAPR LAEYQAYIDF EMKIGDPARI QLIFERALVE NCLVPDLWIR YSQYLDRQ (1-357 aa encoded by BC093784)
靶标信息
The protein encoded by this gene is an RNA-binding nuclear protein that is a tumor-rejection antigen. This antigen possesses tumor epitopes capable of inducing HLA-A24-restricted and tumor-specific cytotoxic T lymphocytes in cancer patients and may be useful for specific immunotherapy. This gene product is found to be an important cellular factor for HIV-1 gene expression and viral replication. It also associates transiently with U6 and U4/U6 snRNPs during the recycling phase of the spliceosome cycle. This encoded protein is thought to be involved in the regulation of mRNA splicing.
仅用于科研。不用于诊断过程。未经明确授权不得转售。
生物信息学
蛋白别名: HIV-1 Tat-interacting protein of 110kDa; hSART-3; KIAA0156; MGC138188; mSART-3; p110 nuclear RNA-binding protein; pretruncated isoform; PRP24 homolog; SART-3; Spliceosome associated factor 3, U4/U6 recycling protein; squamous cell carcinoma antigen recognized by T cells 3; Squamous cell carcinoma antigen recognized by T-cells 3; Tat-interacting protein of 110 kDa; Tip110; Tumor-rejection antigen SART3; unnamed protein product
基因别名: AU045857; DSAP1; KIAA0156; mKIAA0156; P100; p110; p110(nrb); RP11-13G14; SART3; TIP110
UniProt ID: (Human) Q15020, (Mouse) Q9JLI8
Entrez Gene ID: (Human) 9733, (Mouse) 53890, (Rat) 304582